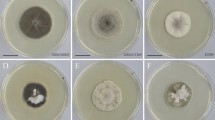
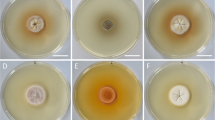

Abstract
Lagena has so far only been known from the scarcely reported but widespread species Lagena radicicola, which is a parasite of root epidermal cells. While it was mostly reported from a wide range of cereals and other grasses, it has been shown to affect some dicot species under, e.g. tobacco and sugar beet. Due to the wide host spectrum under laboratory conditions, there were no attempts to subdivide the genus into several species, even though some morphological differentiation was reported and the species had been found in several continents. During a survey of diatoms, we came across some parasitoids that would have previously been assumed to be members of the genus Lagenidium. The species exhibited rather narrow host specificity in nature. One species was brought into dual culture with host diatoms of the genus Ulnaria, but could not be transferred to other host genera. Surprisingly, phylogenetic analyses revealed that Lagena radicicola was in a sister clade to that formed by the diatom parasitoids, suggesting a versatile pathogenicity of the genus. Interestingly, several phylogenetic lineages only known from environmental sequencing were clustered with the species found in this study, hinting an undiscovered diversity in the genus Lagena.
Similar content being viewed by others
Introduction
Holocarpic oomycetes are a group of neglected but widespread organisms that convert the entire thallus into zoospores upon asexual reproduction (Beakes and Thines 2017). They parasitise a wide spectrum of hosts, including animals, fungi, brown algae, diatoms, red algae, plants, and oomycetes (Buaya and Thines 2020a). Due to the inconspicuous, soil-borne or water-borne nature, and the fact that the vast majority of them seems to be obligate biotrophic, they have so far received much less attention than their aerial or cultivable eucarpic counterparts. The first holocarpic oomycete was discovered in hyphae of oomycetes already in the mid-nineteenth century by Nägeli (1846), who, however, thought that the sporangia where endogenous spore formations in Achlya. Braun (1856) recognised them as parasitic structures and named the causal agent as Chytridium saprolegniae. Cornu (1872) recognised that the parasite was an oomycete and described the genus Olpidiopsis to accommodate the species along several others he discovered. Olpidiopsis species are characterised by releasing motile zoospores from the mature thallus. This is in contrast to another genus of holocarpic oomycetes discovered in 1859 by Schenk (1859), the genus Lagenidium, where the cytoplasmic mass is ejected into a vesicle in which the zoospores form to be released upon its rupture.
After these first reports of holocarpic oomycetes, several studies were conducted in the later nineteenth and also in the first half of the twentieth century (Zopf 1878, 1884; Fischer 1882; Gill 1893; Maurizio 1895; Petersen 1905; Magnus 1905; Butler 1907; Coker 1923; Scherffel 1925; Sparrow 1934, 1936; Tokunaga 1934; Couch 1935; Shanor 1939, 1940; Drechsler 1940; McLarty 1941; Karling 1942, 1943; Canter 1949, 1950; Sparrow and Ellison 1949), which revealed that holocarpic oomycetes are widespread pathogens and parasitoids. Despite of their simple thallus organisation, they were found to exhibit a remarkable diversity in forming both sexual and asexual spores, and holocarpic oomycetes were subdivided into several genera as a consequence (Sparrow 1960).
Those parasites with a pronounced diplanetism, which means that two distinct generations of zoospores are present, were placed in the Saprolegniales. In these parasites, a first generation of zoospores with rather poor swimming abilities is formed that after encystation gives rise to a second generation of zoospores, which are usually reniform and enduring swimmers (Beakes and Thines 2017). Examples for this are the genera Ectrogella and Aphanomycopsis, which infect various diatoms (Scherffel 1925). Those parasites without pronounced diplanetism were placed in the Lagenidiales (Sparrow 1960). In these genera, already the first generation of zoospores is fast-swimming, and if after encystation a new generation of zoospores is formed, it has the same properties as the first one. Examples for this are the genera Lagenidium, Myzocytiopsis, Olpidiopsis, and Lagena (Buaya and Thines 2020a). The first lagenidium-like species were found to infect algae, but later on they were also discovered to infect insects and crustaceans (Dick 2001). The genus Myzocytiopsis infects primarily nematodes (Glockling and Beakes 2006), while the genus Olpidiopsis was initially thought to infect a wide range of organisms including, among others, red algae, diatoms, and oomycetes (Sparrow 1960).
After the turn of the millennium, phylogenetic analyses provided a new view on holocarpic oomycetes, with the study of Cook et al. (2001) challenging for the first time the traditional grouping into the saprolegnialean and the peronosporalean oomycetes, as they found some marine parasites of crustaceans to form the sister clade to all other oomycetes investigated until then (Sekimoto et al. 2007). Later, an even earlier divergence was found for a parasite of brown algae, Eurychasma (Küpper et al. 2006), and for nematode parasitoids of the genus Haptoglossa (Beakes et al. 2006; Hakariya et al. 2007). Subsequently, other holocarpic oomycetes parasitising algae were sequenced that fell outside the crown oomycetes and formed new early diverging lineages (Sekimoto et al. 2008; Gachon et al. 2015). However, as the type species of important genera, such as Olpidiopsis, Ectrogella, and Pontisma, were not included in the phylogenetic analysis until recently, uncertainty regarding the right genus into which to place the species remained (Beakes et al. 2014). However, recent phylogenetic investigations have shown that Olpidiopsis is an early diverging lineage restricted to oomycete hosts, leading to the transfer of species infecting red algae to the genus Pontisma (Buaya et al. 2019a). It is noteworthy that phylogenetic investigations on diatom-infecting oomycetes have revealed that, contrary to the assumption of Dick (2001), these were not forming a monophyletic assemblage, but found to be spread throughout the phylogeny of oomycetes (Thines et al. 2015; Buaya and Thines 2020b; Buaya et al. 2017, 2021). The genus Ectrogella was revealed to indeed belong to the Saprolegniomycetes (Buaya and Thines 2019), which was also the case for Aphanomycopsis (Buaya et al. 2021) and for Lagenisma (Thines et al. 2015). In addition to this, it was also found that some diatom parasitoids formed a distinct, early-diverging lineage of oomycetes and were described as members of a new genus, Miracula (Buaya et al. 2017). Given the high diversity of oomycetes infecting diatoms, with the description of several new species during the past 5 years, the presence of several more lineages known only from environmental sequencing (Garvetto et al. 2018; Hassett et al. 2019), and the high number of known species that could not be included in phylogenetic investigations so far, it seems likely that new lineages of diatom-infecting oomycetes await discovery.
Despite the advances mentioned above, there are still several genera of holocarpic oomycetes poorly studied. This includes also the genus Lagena, which infects roots of grasses (Blackwell 2011). Lagena was first observed on grass roots in Canada and assumed to be associated with brown root rots in various fields and on various hosts (Vanterpool and Ledingham 1930; Truscott 1933). Two different forms were found, one with branched and another one with unbranched hyphae (Truscott 1933). However, because the overall appearance and mode of zoospore release in a lagenidium-like manner were highly similar, they were not considered to be different species (Blackwell 2011). As the pathogen was not thought to be a major concern, it received little attention throughout the next decades. Thus, only sporadic reports were made, notably not restricted to grass hosts or to Northern America (Antoine and Ricaud 1966; Macfarlane 1970; Payne and Asher 1990; Blackwell 2011). Only recently, sequence data for the type species of Lagena, Lagena radicicola, was obtained and showed that the species belongs to the Peronosporales, closely related to the genera Lagenidium and Pythium (Spies et al. 2016). This again highlighted the importance of zoospore formation and release for the taxonomic classification of oomycetes.
Also among diatom parasitic oomycetes, there are some species for which a lagenidium-like zoospore release has been reported (Sparrow 1960). In an attempt to clarify the phylogenetic position of such species, diatoms from various habitats (lakes, rivers, ponds) and geographic locations (temperate Europe and Iceland) were screened for parasitoids. Over the past 3 years several of such oomycetes were found, but only recently we have been successful in establishing a dual culture for one species. It was the aim of the current study to characterise the life-cycle of this species and to clarify the phylogenetic position of other lagenidium-like diatom parasitoids.
Materials and methods
Isolation, characterisation, and establishment of the host and parasite dual culture
Freshwater diatoms were collected from the stream Hliðá, a small tributary to Breiðdalsá close to the Skriðdals og Breiðdalsvegur (old Þoðvegur), near Ásunnarstaðir, south-east Iceland (64°50′5.25″N 14°19′13.16″W), on a small stream in the periphery of Möhnesee lake, Germany (51°29′13.0″N 8°03′13.2″E), and from the river Main (50°06′12.4″N 8°40′18.1″E) in Frankfurt am Main, Germany. Ulnaria acus infected with oomycetes were collected in September 2019 in Iceland, in October 2018 infected Pinnularia viridis samples from the periphery of the Möhnesee lake, and samples from the river Main were taken in August and October 2018. Samples were collected using a 20-μm mesh plankton net (Hydro-Bios, Germany), horizontally towed and by directly scraping algal biofilms from bottom sediments into 1-L plastic bottles, which were subsequently filled half with water from the respective sampling sites. About 10 mL of phytoplankton concentrates were poured into several 15-mL petri-dishes and screened for oomycete-infected diatoms using an inverted compound light microscope (Type AE31, Motic, China). Infected diatoms were individually picked using a 10-μL micropipette (Brandt, Germany), rinsed multiple times in autoclaved deionised water and transferred to 2-mL tubes containing 0.5-mL RNAlater solution (Invitrogen, Thermo Fisher, Lithuania) or 70% ethanol (VWR, France) for subsequent DNA extraction. Approximately 20 to 50 diatoms infected with Lagena from all collection sites were collected this way for DNA extraction. Samples preserved in 70% ethanol were deposited in the herbarium collection of the Senckenberg Museum of Natural History (FR), Cryptogams Section, Frankfurt am Main (see the “Taxonomy” section for accession numbers). Morphological characterisation of the parasites was made as described earlier (Buaya et al. 2021) using a compound light microscope (Imager2, Carl Zeiss Göttingen, Germany) equipped with DIC, and photographs were taken using Zeiss Axiocam MRc5 (Carl Zeiss, Göttingen, Germany). In addition, cellulose presence in the thallus wall of the parasitoids was tested using zinc iodine chloride (Carl Roth GmbH, Germany) solution. The identity of the diatom host was determined either by light microscopy or 18S sequence barcoding as outlined for the oomycetes below.
Axenic host and parasitoid dual cultures were attempted using different enrichment media, e.g. Guillard’s f/2 medium (Guillard and Ryther 1962), DAM medium (Gagneux-Moreaux et al. 2007), freshwater DM medium (Beakes et al. 1988), and WC medium (Guillard and Lorenzen 1972), as previously described (Buaya et al. 2020). Axenic dual culture of the Lagena species from Iceland with its diatom host U. acus was successfully established using Guillard’s f/2 (Sigma-Aldrich, UK) enrichment medium (Guillard and Ryther 1962; Schnepf and Drebes 1977) and double-autoclaved river water. Long-term cultivation was done in a climate chamber (Conviron, CMP 6010, Canada) in 9-cm petri dishes (Sarstedt, Germany) as previously described (Buaya et al. 2019b; Buaya et al. 2020). Once a week, multiple infected diatoms with the parasitoid thallus were inoculated into healthy 2-week-old cultures of U. acus to maintain the cultures. The parasite inoculum originated from a single thallus of an infected U. acus, and the absence of microbial contaminants was confirmed by microscopy.
DNA extraction, PCR amplification, and phylogenetic analyses
DNA extraction was performed using an innuPREP Plant DNA extraction Kit (Analytik Jena, Germany), as previously described (Buaya et al. 2017). Isolates were initially centrifuged at 19 000 g for 2 min at 22 °C to concentrate the cells. Subsequently, RNAlater or 70% ethanol was carefully removed using 1000-μl pipette tips, and 400-μL SLS buffer from the extraction kit was added. About 100 mg of sterile 0.1-mm Silica Glass Beads (Carl Roth GmbH, Germany) were added into each 2-mL tubes (Sarstedt, Germany) and the samples were homogenised at 25 Hz for 25 min in a Retsch Mixer Mill MM 200 (Retsch GmbH, Germany). Subsequent PCR amplification of the nuclear encoding small subunit (nrSSU) was performed as described in Buaya et al. (2019a) using Mango-Taq DNA Polymerase (Bioline, UK) but with the 18S primer pair EUK422-445 and EUK1422-1440_R (Wang et al. 2014). In addition, internal transcribed spacer (ITS) amplicons were obtained as described in Bennett and Thines (2019). Amplicons were sent for sequencing at the laboratory centre of the Senckenberg Biodiversity and Climate Research Centre, Frankfurt am Main (SBiK-F, Germany), using the primer pairs used in the PCR. In addition, direct PCRs were also done as described in Buaya et al. (2019a) for extracted DNA. To obtain high-quality sequences of the oomycetes isolates, PCR amplicons were cloned as previously described (Buaya eat al. 2017). For this, the PCR amplicons were purified using magnetic beads (AMPure XP, Beckman Coulter Inc., USA). Subsequently, PCR amplicons were diluted by a factor of ten, and the mixture was cloned into competent Escherichia coli using a StrataClone TA cloning kit (Agilent Technologies, Santa Clara, USA) following instructions of the manufacturer. Single bacterial colonies were picked into 20 μL molecular grade water (Life Technologies, USA) and colony PCR was carried out with the Mango DNA Polymerase using M13-F and M13-R plasmid primers with amplification conditions set to an initial denaturation at 96 °C for 10 min, 36 cycles at 96 °C for 20 s, 56 °C for 20 s, and 72 °C for 60 s, and concluding with a final elongation at 72 °C for 10 min. Positive clones were sent for sequencing to the laboratory centre of the Senckenberg Biodiversity and Climate Research Centre (Frankfurt am Main, Germany) using M13 (M13-F, M13-R), T3, and T7 plasmid primers. The resulting sequences obtained by the various approaches were assembled and edited using Geneious (version 5.6), and the final 18S sequences were added to the dataset of Buaya et al. (2021) and aligned using muscle (Edgar 2004) as implemented in MEGA7 (Kumar et al. 2016), with a penalty of −600 for gap opening and −4 for gap extension, respectively. The ITS sequence dataset was obtained by similarity searches using the TrEase webserver (http://thines-lab.senckenberg.de/trease/) with several sequences derived from Fiore-Donno and Bonkowski (2021), and the addition of representative additional members of the Peronosporales. Alignments for ITS sequences were done using MAFFT v7 (Katoh and Standley 2013), as implemented on the TrEase webserver. Phylogenetic analyses were done using MEGA6 for Minimum Evolution analysis with 1000 bootstrap replicates, and on the TrEase webserver, using RAxML (Stamatakis 2014) for Maximum Likelihood inference, also with 1000 bootstrap replicates. Bayesian inference was done on the same web server, which implements MrBayes, version 3.2 (Ronquist et al. 2012), running 10 million generations and discarding the first 3 million generations. Subsequently, every 10,000th tree was sampled for calculating posterior probabilities. The sequences obtained in this study were deposited in GenBank under the accession numbers given in the phylogenetic trees. The alignments used in this study are available as Supplementary File 1 (partial nrSSU) and Supplementary File 2 (partial nrITS).
Results
Detection of the parasitoids and establishment of cultures
About 10% of the U. acus diatoms screened from the brook Hliðá were infected by a lagenidium-like oomycete while the other parasitoids occurred at much lower frequency. To allow further propagation of the host diatom and all other diatom species in order to increase chances of re-isolating the target pathogens, field samples were incubated for 3–6 weeks with addition of f/2 medium and kept in a controlled environment as previously described (Buaya et al. 2020). The samples were screened daily, and the presence of holocarpic oomycetes gradually increased on all samples in parallel to the abundance of the host diatoms, but then vanished after 1–2 weeks, after infesting all susceptible hosts. No infections were found in Nitzschia sigmoidea, Cymbella gastroides, Synedra ulna, Gyrosigma sp., and Asterionella sp., which were co-occurring with the infected individuals of U. acus from Icelandic samples, even after several weeks. This is notable as these species were also reported to be host for diatom-infecting oomycetes (Karling 1942; Sparrow 1960). In the German samples, infection was also only found in one diatom species per sample, even if Ulnaria spp., which had been found infected in Iceland, were present in the same sample and incubation was done for several weeks. However, the pennate diatoms Gyrosigma acuminatum and Nitzschia sigmoidea from the German samples were observed to be infected with suspected Diatomophthora gillii and Ectrogella bacillariacearum, respectively, at very low frequency. No sequences of these pathogens could be obtained due to their rarity in the samples. Attempts to establish a stable dual culture containing the hosts and parasites were only successful for the Lagena species from Iceland. After prolonged serial transfers of the host and parasite culture, the susceptible U. acus and U. ulna strains gradually declined in their fitness. New cell lines of U. acus and U. ulna were subsequently isolated from the river Main, in Frankfurt am Main, to replace the declining host strains. However, none of the newly isolated strains was found to be suitable for co-cultivation, as only few individuals got infected. Thus, after 27 months, the pathogen perished.
Morphology and life-cycle observations
Lagena sp. ex Ulnaria acus and U. ulna
The infection cycle of this parasite started with an encysted spore attached on the outer surface of the host frustule of Ulnaria ulna (Fig. 1a, red arrow), which upon germination developed a very fine penetration tube that grew into the host cytoplasm through the girdle bands, often at the central area close to the nucleus. The thalli were naked at an early stage, but once established, underwent rapid growth, elongating into an unbranched tubular amorphous sporangium with tiny refractive granules. At this stage, thalli were surrounded by a colourless, thin, smooth wall, and caused gradual degradation of the host phaeoplasts, often reducing them into golden-green to light-brown residues with chestnut-coloured spots lining along the periphery of the girdle bands (Fig. 1b-e). The silvery amorphous thalli typically occupied almost the whole length of the host frustule and were usually 180–240 μm long by 10–16 μm in diameter, depending on the length of the diatom frustule. Normally, a single host contained one to two unbranched, tubular-fusiform holocarpic thalli (Fig. 1b-e), but occasionally more than 4–6, tightly compacted within the frustule. Prior to zoosporogenesis, the developing thallus became densely granular, and then small vacuoles developed along the whole thallus. These vacuoles subsequently fused and often formed a large swelling where the largest vacuole was situated, which forced apart the valves of the host (Fig. 1c, d), so part of the thalli became extramatrical. Usually, a singular discharge tube with 6–12 μm in length and 6–8 μm in diameter and a somewhat thickened base was formed on the swelling in conjunction with the formation of zoospore initials (Fig. 1e). After some time, the granular contents of the vacuole slowly moved into the orifice of the discharge tube and formed a thin-walled, colourless, spherical vesicle (lagenidium-like). Subsequently, the contents of the vesicle gradually underwent differentiation. During the differentiation, the flagella of the zoospore initials began to move more and more vigorously, until numerous biflagellate reniform zoospores of 5–8 μm in length by 4–6 μm in diameter became visible. Subsequently, the vesicle gradually dissolved by gelatinisation, releasing the zoospores that vigorously swam away individually in an irregular motion. Zoospores swam through the surrounding medium for a few minutes before coming to rest. If not attached to a host, the immotile spores eventually developed into spherical hyaline cysts of 5–8 μm in diameter, with a smooth, and slightly thickened, colourless wall. Their germination and the sexual reproduction of the pathogen were not observed. The entire sporangium of the parasitoid, especially the thickened portion of its discharge tube, tested positive for the presence of cellulose as evidenced by a strong violet to fuchsine colour after staining with a solution of zinc iodine chloride (Fig. 1f).
Microscopic features and development of Lagena ausuennarstadhirensis On Ulnaria acus (f) and U. ulna (all other pictures, ex-type strain). a Start of the infection cycle with an encysted zoospore attached to the host frustule (red arrow). b–e Thallus maturation. f Zoospore development in an extramatrical discharge vesicle. g Emptied thallus stained with zinc iodine chloride. The scale bar equals 50 μm in all pictures
Lagena sp. ex Pinnularia viridis
The lifecycle stages of this parasitoid (Fig. 2a, b) were similar to the previous one. However, thallus formation of this species was highly similar to Aphanomycopsis bacillariacearum (Scherffel 1925; Buaya et al. 2021) in that the thalli were branched, and they neither broke the host valves nor caused hypertrophy. The single discharge tube of variable length and 4–6 μm in diameter was typically apically inserted. Zoospore formation could not be observed in detail, but immotile spores were observed at the bottom of the Petri-dishes after 24 h.
Lagena sp. ex Cymbella gastroides
The infection cycle of this parasitoid (Fig. 2c-f) was similar to the previous ones. However, the cylindrical discharge tube was very short and developed on the apical or subapical end of the hosts (Fig. 2f). Afterwards, the extramatrical vesicle that developed at the orifice of the discharge tube cleaved into bean-shaped biflagellate zoospores that were a bit smaller than in Lagena sp. from Ulnaria spp. (4–7 μm long by 4 μm broad).
Lagena sp. ex Nitzschia sigmoidea
The infection stages of this parasite (Fig. 2g) were overall similar to the ones reported before. However, the singular, very short, cylindrical discharge developed usually in the central area, but also at other locations, depending on the location of the thallus. It is noteworthy that in this species the thallus usually did not extend throughout the entire host cell (Fig. 2g).
Phylogeny
In the phylogenetic reconstructions inferred from nrSSU sequences (Fig 3), the four novel parasitoid species isolated from various diatoms clustered together in a monophyletic clade with Lagena radicicola, the only currently-known member of the genus, with strong support in Minimum Evolution and Bayesian inference. This clade, representing Lagena s.str., clustered together with varying support with Pythium species affecting red algae and two morphologically uncharacterised isolates named as “Lagenidium” in GenBank.
Phylogenetic reconstruction in Minimum Evolution, based on partial nuclear small ribosomal subunit sequences (18S), with bootstrap support values from Minimum Evolution and Maximum Likelihood analyses, as well as posterior probabilities from Bayesian inference, in the respective order. Only bootstrap support >70 % and posterior probabilities >0.9 are given. A minus sign denotes lack of support for the given or an alternate topology
In the phylogenetic reconstruction based on ITS sequences (Fig 4), 39 OTUs derived from environmental sequencing, forming more than 30 distinct phylogenetic lineages, clustered in a monophyletic Lagena clade that received high support in the Minimum Evolution phylogenetic reconstruction. Within this clade, some supported subclades were found. However, it is unclear at present if these are structured according to the hosts infected. The relationship of Lagena to lineages of Pythium s.l. could not be resolved based on partial ITS sequences.
Phylogenetic reconstruction in Minimum Evolution, based on partial internal transcribed spacer (ITS) sequences, with bootstrap support values from Minimum Evolution and Maximum Likelihood analyses, as well as posterior probabilities from Bayesian inference, in the respective order. Only bootstrap support >70% and posterior probabilities >0.9 are given. A minus sign denotes lack of significant support for the given or an alternate topology, an x denotes support for an alternate topology in the corresponding analysis
Taxonomy
Based on life cycle traits, host spectrum, and phylogenetic distinctiveness, the parasitoids of freshwater pennate diatoms from Iceland and Germany discovered in this study were classified as new species of the genus Lagena. An overview of the diagnostic bases is given in Fig. 5.
Lagena ausuennarstadhirensis Buaya & Thines, sp. nov., MycoBank number 844359 (Fig. 1)
Etymology: Named after the locality on Iceland from which the parasitoid was isolated.
Type: Ásunnarstaðir, Skriðdals-og Breiðdalsvegur, Iceland, 12 September 2019, collected by A. Buaya, isolated by M. Thines, FR-0046128, ex-type partial nrSSU ON392451, ex-type partial nrITS ON392438.
Diagnosis: Like all diatom parasitoids investigated in this study, Lagena ausuennarstadhirensis differs from Lagena radicicola by having a G instead of an A at the second position of the partial 18S alignment given in Fig. 5. It differs from Lagena friedmannii by having a T instead of a C at position 153 and an A instead of a G at postion 331, from Lagena dangeardii by one SNP outside of the presented alignment (C instead of T at position −385 of an ungapped alignment extended from the one presented in Fig. 5) and by parasitising Ulnaria species instead of Pinnularia species. It differs from Lagena zopfii by parasitising Ulnaria spp. instead of Cymbella gastroides, and a G instead of an A at position 97, a C instead of a T at position 110, an A instead of a G at position 115, a T instead of a C at position 135, and a G instead of a C at position 167.
Description: Thallus holocarpic, usually one or two, rarely more, endobiotic in Ulnaria acus, but infecting also U. ulna. Thallus naked at an early stage, later walled, unbranched, tubular to fusiform, 180–240 μm long by 10–16 μm in diameter, depending on the length of the diatom host frustule, prior to zoosporogenesis often with a swelling containing a large vacuole, forcing apart the valves of both U. acus and U. ulna., staining fuchsine violet to blue with zinc iodine chloride. Discharge tube tubular, single, with a thickened base, 6–12 μm in length, 6–8 μm in diameter. Zoospore formation lagenidium-like, in a thin-walled vesicle gradually dissolving by gelatinisation, releasing the zoospores. Zoospores biflagellate, reniform 5–8 μm long and 4–6 μm broad, vigorously swimming before coming to a rest and developing into spherical hyaline cysts of 5–8 μm in diameter, with a smooth, and slightly thickened colourless wall if not attached on a host. Cyst germination and sexual reproduction not observed.
Known distribution: Ásunnarstaðir, Iceland
Lagena dangeardii A.T. Buaya & Thines, sp. nov., MycoBank number 844360 (Fig. 2a, b)
Etymology: In honour of P. A. Dangeard, in recognition of his outstanding contributions the knowledge of the parasitoids of unicellular eukaryotes.
Type: Möhnesee lake Germany, 25 October 2018, collected and isolated by A. Buaya, FR-0046141, ex-type partial nrSSU ON392452.
Diagnosis: Like all diatom parasitoids investigated in this study, Lagena dangeardii differs from Lagena radicicola by having a G instead of an A at the second position of the partial 18S alignment given in Fig. 5. It differs from the other known species of Lagena affecting diatoms by parasitising hosts of the genus Pinnularia. It differs from Lagena friedmannii by having a T instead of a C at position 153 and an A instead of a G at postion 331, from Lagena ausuennarstadhirensis by one SNP outside of the presented alignment (T instead of C at position -385 of an ungapped alignment extended from the one presented in Fig. 5), and from Lagena zopfii by a G instead of an A at position 97, a C instead of a T at position 110, an A instead of a G at position 115, a T instead of a C at position 135, and a G instead of a C at position 167.
Description: Thallus holocarpic, normally one, rarely 2–3 endobiotic in Pinnularia viridis, naked at early development, subsequently surrounded by smooth colourless wall, unbranched or branched, nonseptate (4–12 μm in diameter), expanding in almost all parts within the host frustule, disintegrating the host phaeoplast, forming pronounced fragmented chestnut to light brown coloured residues usually deposited in the middle of the girdle band, not causing hypertrophy. Zoospore development not observed, but zoospores develop into resting cysts after some time. Germination of resting cysts and sexual reproduction not observed.
Known distribution: Möhnesee lake, Germany
Lagena friedmannii Buaya & Thines, sp. nov., MycoBank number 844361 (Fig. 2c-f)
Etymology: In honour of I. Friedmann, in recognition of his outstanding contributions to the knowledge of aquatic oomycetes.
Type: DE, Hessen, Frankfurt am Main, river Main, 01 October 2018, collected and isolated by A. Buaya, FR-0046142, ex-type partial nrSSU ON392465.
Diagnosis: Like all diatom parasitoids investigated in this study, Lagena friedmannii differs from Lagena radicicola by having a G instead of an A at the second position of the partial 18S alignment given in Fig. 5. It differs from the other known species of Lagena affecting diatoms by parasitising Cymbella gastroides. It differs from Lagena dangeardii and Lagena ausuennarstadhirensis by having a C instead of a T at position 153 and from Lagena ausuennarstadhirensis, Lagena dangeardii, and Lagena zopfii by having a G instead of an A at postion 331, it further differs from Lagena zopfii by a G instead of an A at position 97, a C instead of a T at position 110, an A instead of a G at position 115, a T instead of a C at position 135, and a G instead of a C at position 167.
Description: Thallus holocarpic, usually one, rarely more than two, endobiotic in Cymbella gastroides. Thallus naked at an early stage, later walled, nonseptate, irregularly tubular, 50–90 μm long by 12–19 μm in diameter, not causing hypertrophy, but disintegrating the host phaeoplast into fragmented, chestnut-coloured to light-brown residues at the girdle band. Discharge tube tubular, single, with thin thickened base, very short, 3–6 μm in diameter. Zoosporogenesis lagenidium-like, forming an extramatrical thin-walled vesicle, releasing the zoospores through dissolution. Zoospores biflagellate, reniform, 4–7 μm in length by 4 μm in breadth, vigorously swimming before coming to a rest and encysting. Resting cyst germination and sexual reproduction not observed.
Known distribution: Main river, Germany
Lagena zopfii A.T. Buaya & Thines, sp. nov., MycoBank number 844362 (Fig. 2g)
Etymology: In honour of W. Zopf, in recognition of his outstanding contributions to the knowledge of parasitoids of diatoms and other microscopic eukaryotes.
Type: D, HE, Frankfurt am Main, river Main, 12 October 2018, collected and isolated by A. Buaya, FR-0046143, ex-type partial nrSSU ON392456.
Diagnosis: Like all diatom parasitoids investigated in this study, Lagena zopfii differs from Lagena radicicola by having a G instead of an A at the second position of the partial 18S alignment given in Fig. 5. It differs from the other species of Lagena from diatoms by its host, Nitzschia sigmoidea, and by an A instead of an G at position 97, a T instead of a C at position 110, a G instead of an A at position 115, a C instead of a T at position 135, and a C instead of a G at position 167.
Description: Thallus holocarpic, usually one, rarely 2–3, endobiotic in pennate diatom Nitzschia sigmoidea. Thallus initially naked, later walled, forming a nonseptate, unbranched, broadly oval to broadly tubular thallus, 19–30μm long by 8–14 μm in diameter, usually not occuping the majority of the space within the host frustule, but disintegrating the host phaeoplast, into fragmented dark orange, chestnut-coloured, and light brown residues, not causing hypertrophy. Discharge tube tubular, single, with thickened base, 4–7 μm in diameter, 10–14 μm long. Zooporogenesis lagenidium-like, forming an extramatrical, short-lived, thin-walled, colourless vesicle, releasing the zoospores upon dissolution. Zoospores biflagellate, reniform 5–8 μm in length, vigorously swimming after release before encystation. Resting cyst germination and sexual reproduction not observed.
Known distribution: Main river, Germany
Discussion
Despite recent advances, holocarpic oomycetes remain relatively poorly known. So far, they have mainly been reported from limnic and marine environments. However, holocarpic oomycetes also thrive in terrestrial habitats such as soil, where the presence of water in soil pores as well as around roots and hyphal threads enables short-distance movement. Currently, apart from some animal parasitoids (e.g. Beakes et al. 2014), just two genera of holocarpic oomycetes are known to inhabit soils, the genera Olpidiopsis (Cornu 1872) and Lagena (Schenk 1859). Olpidiopsis species are predominantly parasites of oomycetes (Buaya et al. 2019a), whereas the sole confirmed member of the genus Lagena infects roots (Blackwell 2011). As the symptoms caused by Lagena radicicola are rather inconspicuous and unspecific (Vanterpool and Ledingham 1930; Truscott 1933), it is only rarely reported. However, it has been reported from four different continents (Vanterpool and Ledingham 1930; Tokunaga 1934; Antoine and Ricaud 1966; Macfarlane 1970; Payne and Asher 1990) and, thus, seems to have a cosmopolitan distribution. A recent study by Fiore-Donno and Bonkowski (2021) has revealed a surprisingly high diversity of OTU lineages closely associated with Lagena radicicola and, thus, were assigned to the genus Lagena in their study. This suggests that there might be various so far undiscovered species in the genus. As the sequences generated by Fiore-Donno and Bonkowski (2021) were derived from soil samples, it is unclear with which hosts these lineages were associated. Even though it is conceivable that those lineages mainly correspond to parasites of roots, other hosts cannot be excluded at present. This is highlighted by the fact that in this study several new species of the clade representing Lagena were found associated with diatoms, which are largely unrelated to angiosperms. As the diatom parasitoids investigated in this study were genetically distinct and discovered in divergent hosts and areas, i.e. Germany and Iceland, it seems likely that there are much more species of Lagena associated with diatoms to be discovered in the future. Considering the present findings, it is conceivable that the species of Lagenidium so far reported from diatoms, e.g. Lagenidium enecans, are in fact members of the genus Lagena, as their zoospore production resembles that of the species characterised here (Zopf 1878; Atkins 1909; Sparrow 1960; Karling 1981). Also, other Lagenidium species with similar zoospore formation and discharge might be found to be belonging to Lagena in future studies, such as some parasites of green algae, e.g. Lagenidium oedogonii (Scherffel 1902). More research into the rather obscure genus Lagena is clearly warranted given its cosmopolitan distribution and ecological versatility, and it seems likely that future studies will reveal it to be highly diverse and widely distributed.
Data availability
Genbank accession numbers and voucher specimen ID issues by the Herbarium Senckenbergianum in Frankfurt am Main, Germany, are given in the “Taxonomy” section.
References
Antoine R, Ricaud C (1966) Cane diseases. Rep Mauritius Sugarcane Indus Res Inst 1965:71–84
Atkins GF (1909) Some fungus parasites of algae. Bot Gaz 48:321–338
Beakes GW, Thines M (2017) Hyphochytriomycota and Oomycota. In: Archibald J, Simpson A, Slamovits C (eds) Handbook of the Protists, 2nd edn. Springer International Publishing, Cham, pp 435–505
Beakes GW, Canter HM, Jaworski GH (1988) Zoospore ultrastructure of Zygorhizidium affluens and Z. planktonicum, two chytrids parasitizing the diatom Asterionella formosa. Can J Bot 66:1054–1067
Beakes GW, Glockling SL, James TY (2006) The phylogeny of oomycete nematode pathogens. In: Meyer W, Price C (eds) Proceedings of the 8th International Mycological Congress. Medimond International, Bologna, pp 7–14
Beakes GW, Glockling SL, James TY (2014) A new oomycete species parasitic in nematodes, Chlamydomyzium dictyuchoides sp. nov.: developmental biology and phylogenetic studies. Fungal Biol 118:527–543
Bennett RM, Thines M (2019) Revisiting Salisapiliaceae. FUSE 3:171–184
Blackwell WH (2011) The genus Lagena (Stramenopila: Oomycota), taxonomic history and nomenclature. Phytologia 93:157–166
Braun A (1856) Über Chrytridium, eine Gattung einzelliger Schmarotzergewächse auf Algen und Infusorien. Abh Königl Akad Wiss Berlin 61:21–84
Buaya A, Thines M (2019) Diatomophthoraceae–a new family of olpidiopsis-like diatom parasitoids largely unrelated to Ectrogella. Fungal Systematics and Evolution 5:113–118
Buaya AT, Thines M (2020a) An overview on the biology and phylogeny of the early-diverging oomycetes. Philipp J Syst Biol 14:1–20
Buaya AT, Thines M (2020b) Diatomophthoraceae – a new family of olpidiopsis-like diatom parasitoids largely unrelated to Ectrogella. FUSE 5:113–118
Buaya AT, Ploch S, Hanic L, Nam B, Nigrelli L, Kraberg A, Thines M (2017) Phylogeny of Miracula helgolandica gen. et sp. nov. and Olpidiopsis drebesii sp. nov. two basal oomycete parasitoids of marine diatoms, with notes on the taxonomy of Ectrogella-like species. Mycol Prog 16:1041–1050
Buaya AT, Ploch S, Inaba S, Thines M (2019a) Holocarpic oomycete parasitoids of red algae are not Olpidiopsis. FUSE 4:21–31
Buaya AT, Kraberg A, Thines M (2019b) Dual culture of the oomycete Lagenisma coscinodisci Drebes and Coscinodiscus diatoms as a model for plankton/parasite interactions. Helgol Mar Res 73:92
Buaya AT, Ploch S, Kraberg A, Thines M (2020) Phylogeny and cultivation of the holocarpic oomycete Diatomophthora perforans comb. nov., an endoparasitoid of marine diatoms. Mycol Prog 19:441–454
Buaya AT, Scholz B, Thines M (2021) Taxonomy and phylogeny of Aphanomycopsis bacillariacearum, a holocarpic oomycete parasitoid of the freshwater diatom genus Pinnularia. Mycol Prog 20:289–298
Butler EJ (1907) An account of the genus Pythium and some Chytridiaceae. Mem Dep Agr India, Bot Ser 1(5):1–160
Canter HM (1949) On Aphanomycopsis bacillariacearum Scherffel, A. desmidiella n.sp., and Ancylistes spp. in Great Britain. Trans Br Mycol Soc 32:162–170
Canter HM (1950) Studies on British chytrids: IX. Anisolpidium stigeoclonii (de Wildeman) n. comb. Trans Br Mycol Soc 33:335–344
Coker WC (1923) The Saprolegniaceae, with notes on other water molds. University of North Carolina Press, Chapel Hill
Cook KL, Hudspeth DSS, Hudspeth MES (2001) A cox2 phylogeny of representative marine Peronosporomycetes (Oomycetes). Nova Hedwig Beih 122:231–243
Cornu M (1872) Monographie des Saprolégniées, étude physiologique et systématique. Bibliothèque de l’École des Hautes Études, Section des Sciences Naturelles, Tome V(1), Art. 3. Librrairie de G. Masson, Paris, France
Couch JN (1935) New or little known Chytridiales. Mycologia 27:160–175
Dick MW (2001) Straminipilous Fungi. Kluwer, Netherlands
Drechsler CE (1940) Three fungi destructive to free-living terricolous nematodes. J Wash Acad Sci 30:240–254
Edgar RC (2004) MUSCLE: multiple sequence alignment with high accuracy and high throughput. Nucleic Acids Res 32:1792–1797
Fiore-Donno AM, Bonkowski M (2021) Different community compositions between obligate and facultative oomycete plant parasites in a landscape-scale metabarcoding survey. Biol Fertil Soils 57:245–256
Fischer A (1882) Untersuchungen über die Parasiten der Saprolegnieen. Jb Wiss Bot 13:286–371
Gachon CM, Fletcher KI, Badis Y, van West P, Mueller DG (2015) The pathogens of brown algae Anisolpidium ectocarpii and Anisolpidium rosenvingei define a new class of marine anteriorly uniciliate oomycetes. Eur J Phycol 50(s1):25–26
Gagneux-Moreaux S, Moreau C, Gonzalez JL, Cosson RP (2007) Diatom artificial medium (DAM): a new artificial medium for the diatom Haslea ostrearia and other marine microalgae. J Appl Phycol 19:549–556
Garvetto A, Nézan E, Badis Y, Bilien G, Arce P, Bresnan E, Gachon CMM, Siano R (2018) Novel widespread marine oomycetes parasitising diatoms, including the toxic genus Pseudo-nitzschia: genetic, morphological, and ecological characterisation. Front Microbiol 9:2918
Gill CH (1893) On an endophytic parasite of diatoms. J Ro Microscop Soc London 1:1–4
Glockling SL, Beakes GW (2006) An ultrastructural study of development and reproduction in the nematode parasite Myzocytiopsis vermicola. Mycologia 98:1–15
Guillard RRL, Lorenzen CJ (1972) Yellow-green algae with chlorophyllide C. J Phycol 8:10–14
Guillard RR, Ryther JH (1962) Studies of marine planktonic diatoms: I. Cyclotella nana Hustedt, and Detonula confervacea (Cleve) Gran. Can J Microbiol 8:229–239
Hakariya M, Hirose D, Tokumasu S (2007) A molecular phylogeny of Haptoglossa species, terrestrial Peronosporomycetes (Oomycetes) endoparasitic on nematodes. Mycosci 48:169–175
Hassett BT, Thines M, Buaya A, Ploch S, Gradinger R (2019) A glimpse into the biogeography, seasonality, and ecological functions of arctic marine Oomycota. IMA Fungus 10:6
Karling JS (1942) The simple holocarpic biflagellate Phycomycetes. Published by Karling JS, New York
Karling JS (1943) The life history of Anisolpidium ectocarpii gen. nov. et sp. nov., and a synopsis and classification of other fungi with anteriorly uniflagellate zoospores. Am J Bot 30:637–648
Karling JS (1981) Predominantly holocarpic and eucarpic simple biflagellate Phycomycetes. J. Cramer, Vaduz
Katoh K, Standley DM (2013) MAFFT multiple sequence alignment software version 7: improvements in performance and usability. Mol Biol Evol 30:772–780
Kumar S, Stecher G, Tamura K (2016) MEGA7: Molecular Evolutionary Genetics Analysis Version 7.0 for Bigger Datasets. Mol Biol Evol 33:1870–1874
Küpper FC, Maier I, Müller DG, Goer SLD, Guillou L (2006) Phylogenetic affinities of two eukaryotic pathogens of marine macroalgae, Eurychasma dicksonii (Wright) Magnus and Chytridium polysiphoniae Cohn. Cryptogam Algol 27:165–184
Macfarlane I (1970) Lagena radicicola and Rhizophydium graminis, two common and neglected fungi. Trans Br Mycol Soc 55:113–416
Magnus P (1905) Über die Gattung, zu der Rhizophydium dicksonii Wright gehört. Hedwigia 44:347–349
Maurizio A (1895) Zur Kenntniss der schweizerischen Wasserpilze nebst Angaben über eine neue Chytridinee. Jahresber Naturf Ges Graubünd Chur 38:9–38
McLarty DA (1941) Studies in the family Woroninaceae – I. Discussion of a new species including consideration of the new genera Pseudoolpidium and Olpidiopsis. Bull Torrey Bot Club 68:49–66
Nägeli C (1846) Zellkerne, Zellenbildung und Zellenwachstum bei den Pflanzen (Fortsetzung und Schluss). Z Wiss Bot 3–4:22–93
Payne PA, Asher MJC (1990) The incidence of Polymyxa betae and other fungal root parasites of sugar-beet in Britain. Pl Pathol 39:443–451
Petersen HE (1905) Contributions a la connaissance des Phycomycetes marins (Chytridineae Fischer). Overs Kong Dansk Videnskab Selsk Forhandl 5:439–188
Ronquist F, Teslenko M, van der Mark P, Ayres DL, Darling A, Hohna S, Larget B, Liu L, Suchard MA, Huelsenbeck JP (2012) MrBayes 3.2: efficient Bayesian phylogenetic inference and model choice across a large model space. Syst Biol 6:539–542
Schenk (1859) Algologische Mittheilungen V. Über Pythium Pringsheim. Verh Phys Medic Ges Würzbg 9:12–31
Scherffel A (1902) Mycologische und algologische Notizen. Hedwigia 41:105–107
Scherffel A (1925) Endophytische Phycomyceten-Parasiten der Bacillariaceen und einige neue Monadinen. Ein Beitrag zur Phylogenie der Oomyceten (Schroter). Arch Protistenkd 52:1–141
Schnepf E, Drebes G (1977) Über die Entwicklung des marinen parasitischen Phycomyceten Lagenisma coscinodisci (Lagenidiales). Helgol Wiss Meeresunters 29:291–301
Sekimoto S, Hatai K, Honda D (2007) Molecular phylogeny of an unidentified Haliphthoros -like marine oomycete and Haliphthoros milfordensis inferred from nuclear-encoded small- and large-subunit rRNA genes and mitochondrial-encoded cox2 gene. Mycosci 48:212–221
Sekimoto S, Yokoo K, Kawamura Y, Honda D (2008) Taxonomy, molecular phylogeny, and ultrastructural morphology of Olpidiopsis porphyrae sp. nov. (Oomycetes, Straminipiles), a unicellular obligate endoparasite of Bangia and Porphyra spp. (Bangiales, Rhodophyta). Mycol Res 112:361–374
Shanor L (1939) Studies in the genus Olpidiopsis. II. The relationship of Pseudolpidium Fischer and Olpidiopsis (Cornu) Fischer. J Elisha Mitchell Sci Soc 55:179–195
Shanor L (1940) Studies in the genus Olpidiopsis. III. Some observations on the host range of certain species. J Elisha Mitchell Sci Soc 56:165–176
Sparrow FK (1934) Observations on marine Phycomycetes collected in Denmark. Dansk Bot Ark 8:1–24
Sparrow FK (1936) Biological observations on the marine fungi of Woods Hole waters. Biol Bull 70:236–263
Sparrow FK (1960) Aquatic Phycomycetes. The University of Michigan Press USA
Sparrow FK, Ellison B (1949) Olpidiopsis schenkiana and its hyperparasite Ectrogella besseyi n. sp. Mycologia 41:28–35
Spies CF, Grooters AM, Lévesque CA, Rintoul TL, Redhead SA, Glockling SL, Chen CY, De Cock AW (2016) Molecular phylogeny and taxonomy of Lagenidium-like oomycetes pathogenic to mammals. Fungal Biol 120:931–947
Stamatakis A (2014) RAxML version 8: a tool for phylogenetic analysis and post-analysis of large phylogenies. Bioinf 30:1312–1313
Thines M, Nam B, Nigrelli L, Beakes G, Kraberg A (2015) The diatom parasite Lagenisma coscinodisci (Lagenismatales, Oomycota) is an early diverging lineage of the Saprolegniomycetes. Mycol Prog 14:75
Tokunaga Y (1934) Notes on the Lagenidiaceae in Japan. Trans Sapporo Nat Hist Soc 12:119–123
Truscott JHL (1933) Observations on Lagena radicicola. Mycologia 25:263–265
Vanterpool TC, Ledingham GA (1930) Studies on “browning” root rot of cereals. I. The association of Lagena radicicola n. gen.; n. sp., with root injury of wheat. Can J Res 2:171–194
Wang Y, Tian RM, Gao ZM, Bougouffa S, Qian PY (2014) Optimal eukaryotic 18S and universal 16S/18S ribosomal RNA primers and their application in a study of symbiosis. PLoS One 9:e90053
Zopf W (1878) Über einem neuen parasitischen Phycomyceten aus der Antheilung der Oosporeen. Mitt V Prov Brandenb 20:77–79
Zopf W (1884) Zur Kenntniss der Phycomyceten. I. Zur Morphologie und Biologie der Ancylisteen und Chytridiaceen. Nov Act Acad Caes Leopold-Carolin Germ Nat Cur 47:143–236
Acknowledgements
The authors are grateful to Bettina Scholz for continued support with logistics on Iceland. We thank two anonymous reviewers for their valuable comments that helped greatly improve the manuscript.
Funding
Open Access funding enabled and organized by Projekt DEAL. ATB was supported by DAAD. MT is supported by the German Science Foundation, DFG (Th1632/22-1).
Author information
Authors and Affiliations
Contributions
MT and ATB conceived the study. MT and ATB performed collections and isolations. ATB did the morphological characterisations and measurements. ATB performed PCR and sequencing. MT performed the phylogenetic reconstructions and provided the molecular diagnoses. MT wrote the draft of the manuscript with contributions from ATB. Both authors agreed on the submission of the manuscript.
Corresponding authors
Ethics declarations
Ethics approval and consent to participate
Not applicable.
Consent for publication
Not applicable.
Competing interests
The authors declare no competing interests.
Additional information
Section Editor: Tanay Bose
Publisher’s note
Springer Nature remains neutral with regard to jurisdictional claims in published maps and institutional affiliations.
Rights and permissions
Open Access This article is licensed under a Creative Commons Attribution 4.0 International License, which permits use, sharing, adaptation, distribution and reproduction in any medium or format, as long as you give appropriate credit to the original author(s) and the source, provide a link to the Creative Commons licence, and indicate if changes were made. The images or other third party material in this article are included in the article's Creative Commons licence, unless indicated otherwise in a credit line to the material. If material is not included in the article's Creative Commons licence and your intended use is not permitted by statutory regulation or exceeds the permitted use, you will need to obtain permission directly from the copyright holder. To view a copy of this licence, visit http://creativecommons.org/licenses/by/4.0/.
About this article
Cite this article
Thines, M., Buaya, A.T. Lagena—an overlooked oomycete genus with a wide range of hosts. Mycol Progress 21, 66 (2022). https://doi.org/10.1007/s11557-022-01818-9
Received:
Revised:
Accepted:
Published:
DOI: https://doi.org/10.1007/s11557-022-01818-9